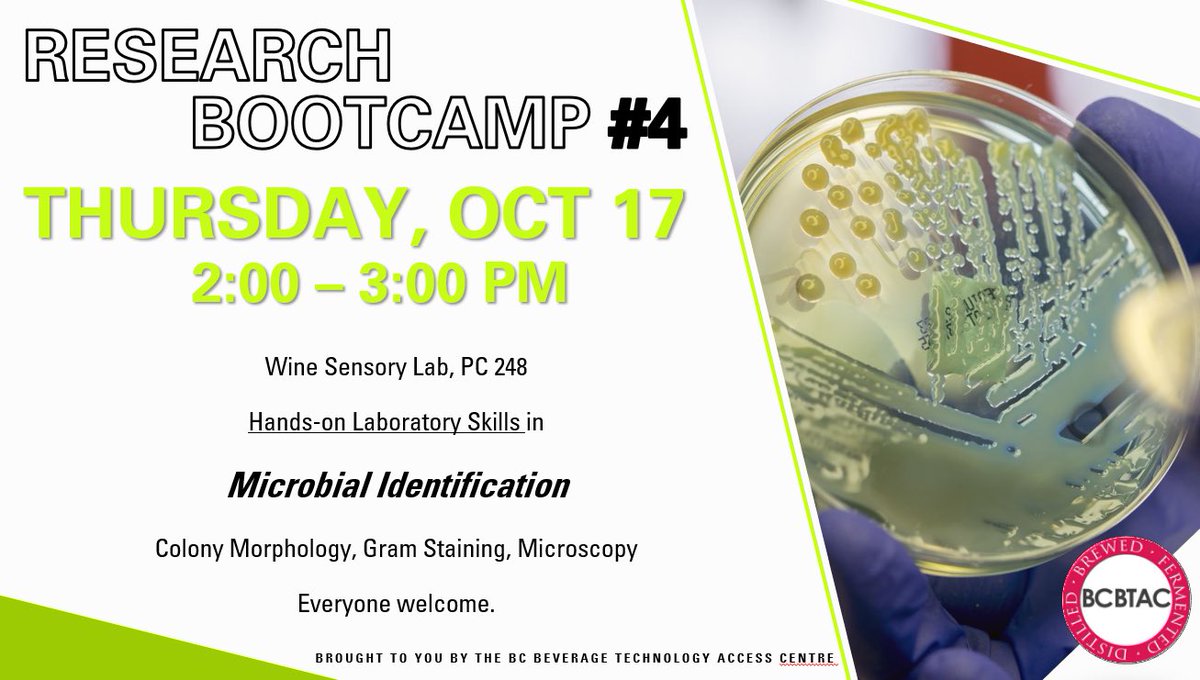
BC Beverage Technology Access Centre tweet media

🚨 #SustainabilityAlert |
🌐 Spots are disappearing fast! Don’t be left behind in the green revolution. Click the link below to register NOW and secure your place at the forefront of change!
BCBTACTOTAWEBINAR.eventbrite.ca
#BCBTACWebinar #SustainableTourism #ActOnClimate
English